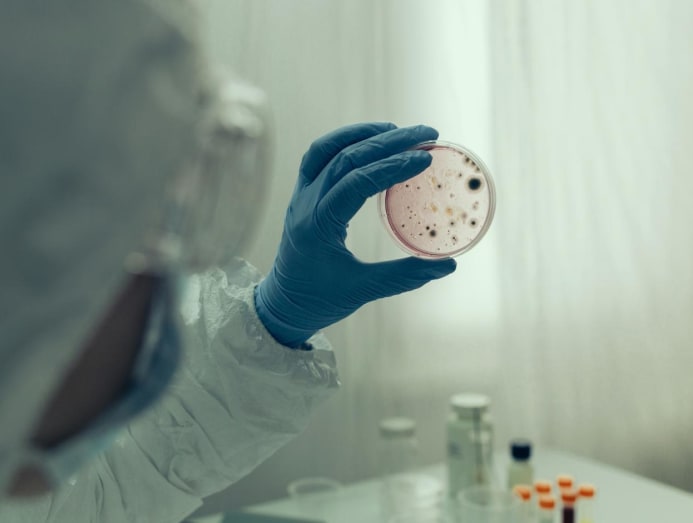

From flu to pneumonia: Why it can happen and how to stay safe
How likely is flu-related pneumonia to happen to you? What are the symptoms to look out for when they can be similar to those of a cold or flu? And when should you immediately head to the A&E department?

(Photo: iStock/visualspace)

This audio is generated by an AI tool.
What causes influenza to progress to pneumonia? That’s a question many healthy adults don’t ask because you can usually count on your immune system to defeat the flu virus.
Yes, you’ll have to endure about five to seven days of sore throat, a runny or stuffy nose, fever, headaches, muscle aches and/or body chills to recover. But you’ll be no worse for wear once you do.
Unfortunately, it wasn’t the outcome for Taiwanese artiste Barbie Hsu, 48, who recently died from flu-related pneumonia while on a family holiday in Japan. Hsu was reported to have a history of epilepsy and an underlying heart issue known as mitral valve prolapse.
In Singapore, pneumonia is no trivial matter. According to the Ministry of Health, pneumonia is the second-most common cause of death locally after cancer. But what exactly is pneumonia and when does a bout of flu become fatal to you? Find out from the doctors.

WHAT IS PNEUMONIA?
Pneumonia is a serious infection of the lungs, which according to Cleveland Clinic, causes your lung tissues to get inflamed, swell, and produce fluid or pus in the air sacs. The infection can affect the lungs in one or more sections, or in patches throughout both lungs, noted Johns Hopkins Medicine.
Pneumonia can range in seriousness from mild to life-threatening, according to Mayo Clinic. Mild signs can emulate those of a cold or flu that last longer than a week. But in serious cases where there is fluid in the lungs (pulmonary oedema), you’d feel like you’re suffocating and would struggle with every breath.
The viruses behind the common cold, flu and COVID-19 aren’t the only culprits of pneumonia. According to Johns Hopkins Medicine, there can be as many as 30 different causes and they are grouped into viral causes (including the cold, flu and COVID-19), bacterial causes (most commonly streptococcus pneumoniae) and fungal causes (likely inhaled from the soil or bird droppings).
HOW DOES FLU DEVELOP INTO PNEUMONIA?
Flu can progress to pneumonia in two ways, said Dr Valencia Lim, a consultant with National University Hospital’s Department of Medicine, Division of Respiratory And Critical Care Medicine. One, the flu virus can advance from your upper respiratory tract to your lungs, causing viral pneumonia, she said.
Two, “viral infections (such as the flu) damage the airways and weaken your immune system, increasing your susceptibility to bacterial infections”, said Dr Lim, adding that such secondary bacterial infection can occur in up to 20 per cent of individuals with influenza.
“Basically, if your immune system is already weakened, maybe you're stressed, not sleeping well, or have other health issues, it's more likely that the flu could progress to pneumonia,” said Dr Andrew Fang, a family physician with Doctor Anywhere.
For a relatively healthy adult, he said, it could take a few days to a week for pneumonia symptoms to develop.
Despite its high occurrence, “pneumonia is not always fatal”, said Dr Lim. “In severe cases where hospitalisation is required, mortality can be up to 20 per cent. Cases that require ICU care have a higher mortality of up to 40 per cent.”
CAN A COLD ALSO PROGRESS TO PNEUMONIA?
“While this scenario is less common, a cold (which is also caused by a virus) can sometimes progress to pneumonia,” said Dr Fang. “A cold is a milder infection compared to the flu, but it can still weaken your defences. Sometimes, other bacteria present might also take advantage of the weakened state and infect the lungs.”
That’s the reason why individuals with a weakened immune system, such as those on immunosuppressive medications, as well as patients with chronic medical conditions such as heart disease and kidney disease are vulnerable to pneumonia, said Dr Lim.
WHAT ARE PNEUMONIA’S SYMPTOMS THAT COULD BE MISTAKEN FOR A COLD OR FLU?
“Pneumonia can mimic a cold or flu with cough, fever and body aches,” said Dr Fang, who advised looking out for pneumonia through the list of symptoms below. If you have one or more of them, see a general practitioner as soon as possible, he said.
And head to the hospital for further evaluation if the signs do not improve even after antibiotic use, said Dr Lim.

- A very high and/or persistent fever, especially if your fever doesn't subside after a few days.
- You're struggling to catch your breath or feel breathless with minimal effort.
- Chest pain, especially when you breathe or cough.
- Oxygen levels that are lower than 95 per cent on your home oximeter.
DOES HAVING PNEUMONIA AUTOMATICALLY WARRANT HOSPITALISATION?
Not always, said both Dr Lim and Dr Fang. Mild cases may be treated with antibiotics (if the cause is bacterial) and rest.
“Hospitalisation is usually warranted in patients with other underlying health conditions as pneumonia can potentially worsen in these individuals,” said Dr Lim. You may also be admitted “if you have severe symptoms like difficulty breathing or a high fever”, said Dr Fang.
In the hospital, you’re likely to undergo tests such as a chest X-ray or blood tests to confirm pneumonia. Other tests may include viral swabs, respiratory cultures and molecular tests for bacteria, said Dr Lim. Treatment typically involves intravenous antibiotics.
“It takes about four to six weeks for individuals to feel completely well and for any chest X-rays to show resolution,” she said. “In healthy individuals who recover from an episode of pneumonia, they are not more susceptible to future infections.”

HOW CAN YOU SAFEGUARD YOURSELF FROM PNEUMONIA WHEN YOU’RE TRAVELLING OR ABOUT TO?
"Pneumonia itself isn’t contagious but the bacteria and viruses that cause it are," said Dr Andrew Lee, a family physician and associate consultant with National Healthcare Group Polyclinics. So "preventing the flu is a good way to reduce the risk of pneumonia", he said.
Personal hygiene measures such as washing your hands, using an alcohol-based hand sanitiser, and wearing a mask in crowded places can help to protect you. But the best way to protect yourself from catching the sniffles is to get up-to-date with your flu shots, said the doctors.
Typically, the flu vaccine takes at least two weeks to work, said Dr Lee. “After a single administration of the flu shot, the level of antibodies and effectiveness of the vaccine will peak in two to four weeks and decrease over time,” he said. “Hence, it is recommended for the flu shot to be taken two to four weeks before travelling.”
If you catch the flu while overseas, seek medical attention promptly, said Dr Fang, especially if you have a medical history. “Early treatment with antivirals can shorten the course and severity of the flu,” said Dr Lim. Doing so may also minimise the odds of the flu progressing to lung infection, he said.







